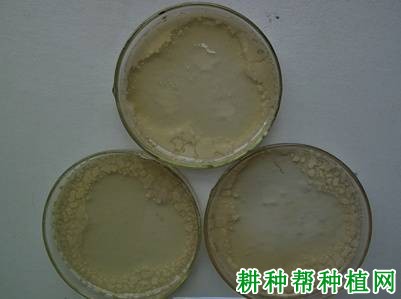

磷细菌
肥料(phosphate bacteria fertilizer),是指能把土壤中难溶性的磷转化为作物能利用的有效磷素营养,又能分泌激素刺激作物生长的活体微生物制品。这类微生物施入土壤后,在生长繁殖过程中会产生一些有机酸和酶类物质,能分解土壤中矿物态磷、被固定的磷酸铁、磷酸铝和磷酸钙等难溶性磷以及有机磷,使其在作物根际形成一个磷素供应较为充分的微区域,从而增强土壤中磷的有效性,改善作物的磷素营养,为农作物的生长提供有效态磷元素,还能促进固氮菌和硝化细菌的活动,改善作物氮素营养。目前,对磷细菌
肥料的解磷机理还不十分明确,对此类微生物施入土壤后的活动和消长动态以及解磷作用发挥的条件也不十分了解,加上菌剂质量不能保证,因而磷细菌
肥料在生产应用时受到很大限制。
肥料?" alt="什么是磷细菌肥料?"> 肥料?" alt="什么是磷细菌肥料?">
肥料?" alt="什么是磷细菌肥料?"> 1、有机磷细菌
肥料是指能在土壤中分解有机态磷化物(卵磷脂、核酸等)的有益微生物经发酵制成的微生物
肥料。分解有机态磷化物的细菌有芽孢杆菌属中的种和类芽孢杆菌属中的种。
2、无机磷细菌
肥料是指能把土壤中难溶性的不能被作物直接吸收利用的无机态磷化物溶解,转化为作物可以吸收利用的有效态磷化物。分解无机态磷化物的细菌有假单胞属中的种、产碱菌属中的种和硫杆菌属中的种。
按剂型不同分为液体磷细菌
肥料、固体粉状磷细菌
肥料和颗粒状磷细菌
肥料。目前采用最多的菌种有巨大芽孢杆菌、假单胞菌和无色杆菌等。
肥料?" alt="什么是磷细菌肥料?"> 肥料?" alt="什么是磷细菌肥料?">
肥料?" alt="什么是磷细菌肥料?"> 通过施用磷细菌
肥料,使固定在土壤中的难溶性磷和有机磷化物转化成作物能吸收利用的有效磷,改善作物磷素营养;同时,解磷细菌生命活动分泌的维生素、异生长素和类
赤霉酸一类的刺激性物质促进作物生长;对环境无污染,有利于提高产品品质。
肥料?" alt="什么是磷细菌肥料?"> 肥料?" alt="什么是磷细菌肥料?">
肥料?" alt="什么是磷细菌肥料?"> 磷细菌
肥料的质量标准为国家农业行业标准,代号为:NY 412—2000。
1、菌种的有效性用于生产磷细菌
肥料的菌种,必须是从国家菌种中心或国家科研单位引进的,并经过鉴定对动物和植物均无致病作用的非致病菌菌株。这些菌株在含有卵磷脂或磷酸三钙的琼脂平板上培养,能观察到明显的溶磷圈;发酵培养后解磷量与不接菌对照比较有显著差异(P≤0.05)。
①有机磷细菌。芽孢杆菌属的细菌为革兰氏染色阳性,能产生抗热的芽抱,为椭圆形或柱形周生或侧生鞭毛,能运动,能产生接触酶。 -
②无机磷细菌。假单胞菌属中的细菌为革兰氏染色阴性杆菌, 极生的单鞭毛或丛鞭毛,能运动,接触酶阳性。此属中的部分菌株为致病菌,必须进行严格的菌种鉴定后才能用于生产。产碱菌属的细菌,细胞呈杆状,1~4根周生鞭毛,能运动,革兰氏染色呈阴性,接触酶阳性。硫杆菌的菌为革兰氏染色阴性小杆菌,单根极生鞭毛,能运动,严格自养。
2、液体磷细菌
肥料技术指标有液体磷细菌
肥料技术指标、固体(粉状)磷细菌
肥料技术指标和固体(颗粒)磷细菌
肥料技术指标如下图。
肥料?" alt="什么是磷细菌肥料?"> 肥料?" alt="什么是磷细菌肥料?">
肥料?" alt="什么是磷细菌肥料?"> 标准对包装、标识、运输和贮存规定如下。
①液体
肥料小包装用塑料瓶或玻璃瓶,大包装用塑料桶。固体
肥料用不透明聚乙烯塑料包装。颗粒磷细菌
肥料亦可用编织袋包装。外包装采用纸箱,箱外用尼龙打包带加固。
②每箱(袋)产品中附有产品合格证和使用说明书,在使用说明中标明使用方法、用量及注意事项。
肥料?" alt="什么是磷细菌肥料?"> 肥料?" alt="什么是磷细菌肥料?">
肥料?" alt="什么是磷细菌肥料?"> 磷细菌
肥料可以用作种肥(浸种、拌种)、
基肥和追肥,使用量以产品说明书为准。
1、拌种:固体菌肥按每亩1~1.5千克,加水2倍稀释成糊状,液体菌肥按每亩0.3~0.6千克,加水4倍稀释搅匀后,将菌液与种子拌匀,晾干后即可播种,防止阳光照射。也可先将种子喷湿,再拌上磷细菌肥,随拌随播,播后覆土,若暂时不用,应阴凉覆盖保存。
2、蘸秩根:水稻秩苗每亩用2~3千克的磷细菌肥,加细土或河泥及少量草木灰,用水调成糊状,蘸根后移栽。处理水稻秩田除蘸根外,最好在秩田播种时也用磷细菌
肥料。
3、作
基肥:每亩用2千克左右的磷细菌肥,与堆肥或其他
农家肥料拌匀后沟施或穴施,施后立即覆土。也可将
肥料或肥液在作物苗期追施于作物根部。
4、作追肥:在作物开花前施用为宜,菌液要施于根部。
①磷细菌适宜生长的温度为30~37℃,适宜的酸碱度为PH = 7.0~7.5,应在土壤通气良好,水分适当,温度适宜(25~37℃), pH = 6~8条件下施用。
②磷细菌
肥料在缺磷但有机质丰富的高肥力土壤上施用,或与
农家肥料、固氮菌肥、抗生菌肥配合施用效果更好;与磷矿粉合用效果较好。
③与不同类型的解磷菌(互不拮抗)复合使用效果较好;在酸性土壤中施用,必须配合施用大量有机
肥料和石灰。
⑤贮存时不能暴晒,应放于阴凉干燥处。
⑥拌种时应使每粒种子都蘸上菌肥,随用随拌,暂时不播时放在阴凉处覆盖好。
